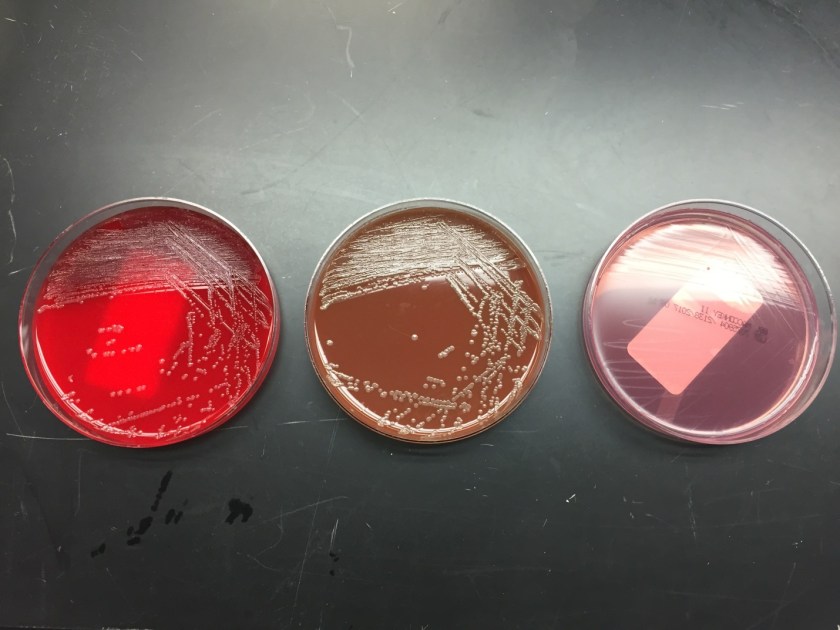
pastmult2

Case History
A 42 year old male presented to the emergency department with a chief complaint of bilateral lower extremity rash. The rash initially began on the dorsum of the patient’s foot, but progressively worsened over the past two weeks. He denied fevers, chills or night sweats. Additionally, he denied any trauma to his legs, burns or exposure to bodies of water. He reported no sick contacts or recent travel and lives at home with his sister and pet dog. His past medical history was significant for squamous cell carcinoma of the oropharynx and alcoholic cirrhosis. On physical exam, he was noted to have extensive cellulitis with the sloughing of skin. Imaging found no acute osteomyelitis or evidence of necrotizing fasciitis. Lab work showed a white count of 17.1 TH/cm2 and elevated ESR and CRP values. He was admitted and started on broad spectrum antibiotics, vancomycin and meropenem. Wound and blood cultures were collected.
Laboratory Identification

The wound culture as well as two blood culture bottles showed growth of the same organism. Gram stain revealed Gram negative coccobacilli that varied from ovoid to short rods. The organism grew on blood and chocolate agars, but not on MacConkey, despite being a Gram negative rod (fastidious pattern). The colonies were non-hemolytic and opaque in appearance. The isolate was positive for catalase, oxidase and indole. MALDI-TOF MS identified the isolates as Pasteurella multocida.
Discussion
Pasteurella spp. are Gram-negative, facultative anaerobic, coccobacilli capable of fermentation. This organism is often found as part of the normal flora of many healthy animals including cats and dogs. P. multocida and P. canis are the most frequently isolated species of the genus. Both of these species are pathogenic in humans. The majority of human infections are wound infections associated with cat (most commonly) & dog bites and scratches. These often result in localized cellulitis and lymphadenitis. Furthermore, rare infections have been reported which include septic arthritis and osteomyelitis, prosthetic joint infection, meningitis, respiratory tract infections, endocarditis, sepsis and bacteremia, and perinatal infections. Systemic infection usually occurs in immunocompromised patients, particularly those with underlying hepatic disease and cirrhosis.
P. multocida is readily recovered by standard media in the clinical microbiology laboratory, growing well on 5% sheep’s blood and chocolate agars, but poorly on MacConkey agar. After overnight incubation on blood agar, small gray colonies with a characteristic musty odor are present. This characteristic musty odor is caused by the production of indole. P. multocida is also oxidase positive and catalase positive. Susceptibility testing for P. multocida from bite wounds in not routinely recommended as these infections most like represent polymicrobial infections and empiric therapy is usually effective. Susceptibility testing should be performed on isolates from normally sterile sites. P. multocida is generally susceptible to penicillin, broad spectrum cephalosporins, tetracyclines, quinolones, trimethoprim-sulfamethoxazole and azithromycin. Resistance has been documented with oxacillin, cephalexin, erythromycin and clindamycin.
In the case of our patient, susceptibility testing was performed by disk diffusion and was susceptible to all the antibiotics listed above with the exception of erythromycin. It was thought he acquired this infection from the family dog licking his feet, with his liver cirrhosis placing him at an increased risk for bacteremia. He was received IV ampicillin/sulbactam for 10 days before being transitioned to an oral regimen for an additional 4 days.

Brooke Sims, MD, is a Cytology Fellow at the University of Mississippi Medical Center.

-Lisa Stempak, MD, is an Assistant Professor of Pathology at the University of Mississippi Medical Center in Jackson, MS. She is certified by the American Board of Pathology in Anatomic and Clinical Pathology as well as Medical Microbiology. She is the director of the Microbiology and Serology Laboratories. Her interests include infectious disease histology, process and quality improvement and resident education.